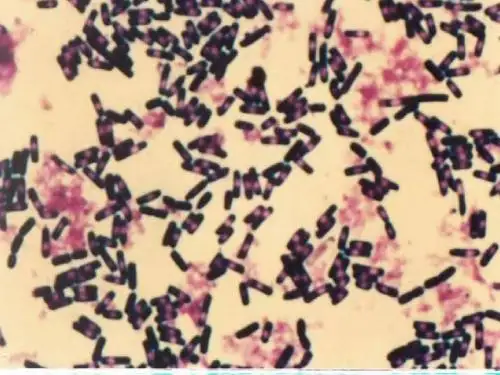

北师大版八年级下册语文课件 细菌的启示
合集下载
北师大版(2016)八年级语文下册第3课《细菌的启示》课件(共31张PPT)

解释下列词语:
1.不计其数:无法计算数字,形容很多。
2.名副其实:名称或名声与实际相符合。
3.不可匹敌:不能相当或不能等同。
4.得天独厚:独具特殊优越的自然条件。 5.不卑不亢:既不自卑,也不高傲,形容言 行自然、得体。 6.不温不火:形容人心情平和,待人接物不 冷漠也不激动,不过火。
7.一以贯之:用一个根本性的事理贯通事情的
作者简介
郑也夫,1950年生,
现为中国人民大学社会 学系教授、博导。主要 著作有《走出囚徒困境》 《代价论》《信任论》。 本文是作者2003年5月12 日“非典”期间在中国 人民大学作的一次精彩 演讲。
预习设计
注意下列字的读音、字形:
摄取( shè) 反刍(chú) 发酵( jiào) 奶酪(lào ) 繁衍( yǎn) 豁免(huò) 砥砺( dĭ lì) 喷嚏( tì) 根瘤菌( liú) 巅峰(diān) 咀嚼( jǔ jué)
②寄生显然是生物世界中重要的生存策略之一。 不能。说明除了这一种外还有其他策略,如果 去掉,就成了只有一种了。
③“差不多所有动物都被寄生者,谁也不能豁 免”中的“差不多”和“所有”是否矛盾?为 什么?
不矛盾。这里作者是强调被寄生的动物范围之 大,用“差不多”限制强调“所有”。 ⑸说说文中划线句子有何作用?
太自卑,说明你还挺有生命力的,石头上能寄生东西
吗?不能。沙漠里能寄生东西吗?难呀! ⑴用一句话概括这两段文字的内容。 寄生的策略极其简单及它是生物界生存的重要的策略 之一。 ⑵病菌的起源是怎样的? 从一种复杂的寄生物退化为简单的寄生物。 ⑶为什么说病菌是寄生物的最简单的? 因为病毒的寄生简单到不需要行走能力,乃至消化能 力,就剩下两样东西:食、性。 ⑷下列加点词语能否去掉,为什么? ①寄生的策略极其简单。 不能。“极其”在句中起限制作用,说明了重要的程 度。如果去掉,则不能准确表明简单的程度。
公开课教案教学设计课件北师大初中语文八下《细菌的启示》PPT课件

谦受益,满招损。
骄傲自满是我们的一座可怕的陷阱;而且,这个陷 阱是我们自己亲手挖掘的。 —— 老舍
尺有所短;寸有所长。物有所不足;智有所不明。 —— 屈原
• 1、正视自己的长处,扬长避短, • 2、正视自己的缺点,知错能改, • 3谦虚使人进步, • 4、人应有一技之长, • 5、自信是走向成功的第一步, • 6强中更有强中手,一山还比一山高, • 7艺无止境 • 8、宝剑锋从磨砺出,梅花香自苦寒来,刻苦
性格: 自矜(骄傲)
取置覆酌沥
对比
谦虚
道理: 熟能生巧,即使有什么长处也不必骄傲自满。
课外延伸
1、联系生活、学习,说说熟能生巧 的事例。
2、你认为一个人应该如何看待自己 的长处?又如何看待他人的长处?
三人行,必有我师焉。 择其善者而从之,其不善者而改之。
人外有人,天外有天。 取人之长,补己之短。 自满人十事九空,虚心人万事可成。
说明文的分类 从对象上:事物说明文、事理说明文 从语言上:生动性说明文、平实性说 明文 说明文的结构
总分式 递进式
细菌的性质和特征
1、细菌的历史最古老; 2、细菌无所不在; 3、细菌发挥着重要作用; 4、细菌的不可毁灭性; 5、细菌的生存策略多;
细菌对人类进步观的挑战表现在 哪些方面?
1、人类的进步与细菌的简 单化、退化。
读准下列词语
• 反刍 发酵 奶酪 愚蠢
打喷嚏
一小撮 巅峰
豁免 不卑不亢 不瘟不火
• 束手待毙 砥砺 根瘤菌 觅食 笨拙 唾液 繁衍
不计其数:无法计算数字,形容很多。
名副其实:名称或名声与实际相符合。
元老 :称某一领域中年龄长、资历高的人。
可观:指达到了比较高的程度。
骄傲自满是我们的一座可怕的陷阱;而且,这个陷 阱是我们自己亲手挖掘的。 —— 老舍
尺有所短;寸有所长。物有所不足;智有所不明。 —— 屈原
• 1、正视自己的长处,扬长避短, • 2、正视自己的缺点,知错能改, • 3谦虚使人进步, • 4、人应有一技之长, • 5、自信是走向成功的第一步, • 6强中更有强中手,一山还比一山高, • 7艺无止境 • 8、宝剑锋从磨砺出,梅花香自苦寒来,刻苦
性格: 自矜(骄傲)
取置覆酌沥
对比
谦虚
道理: 熟能生巧,即使有什么长处也不必骄傲自满。
课外延伸
1、联系生活、学习,说说熟能生巧 的事例。
2、你认为一个人应该如何看待自己 的长处?又如何看待他人的长处?
三人行,必有我师焉。 择其善者而从之,其不善者而改之。
人外有人,天外有天。 取人之长,补己之短。 自满人十事九空,虚心人万事可成。
说明文的分类 从对象上:事物说明文、事理说明文 从语言上:生动性说明文、平实性说 明文 说明文的结构
总分式 递进式
细菌的性质和特征
1、细菌的历史最古老; 2、细菌无所不在; 3、细菌发挥着重要作用; 4、细菌的不可毁灭性; 5、细菌的生存策略多;
细菌对人类进步观的挑战表现在 哪些方面?
1、人类的进步与细菌的简 单化、退化。
读准下列词语
• 反刍 发酵 奶酪 愚蠢
打喷嚏
一小撮 巅峰
豁免 不卑不亢 不瘟不火
• 束手待毙 砥砺 根瘤菌 觅食 笨拙 唾液 繁衍
不计其数:无法计算数字,形容很多。
名副其实:名称或名声与实际相符合。
元老 :称某一领域中年龄长、资历高的人。
可观:指达到了比较高的程度。
北师大版语文八年级下册课件:第3课《细菌的启示》

细菌有哪些性质和特征?
细菌的性质和特征 1、细菌的历史最古老; 2、细菌无所不在; 3、细菌发挥着重要作用; 4、细菌的不可毁灭性; 5、细菌的生存策略多;
整体感知 重点交流
细菌对人类进步观的挑战表 现在哪些方面?
、生物的进化有两个方向:往 简单化走或者往复杂化走。
、人类所谓的没有美感、不舒坦、 没有尊严、恶心的寄生却是生物 世界中重要的生存策略之一。
炭疽(jū)细菌感染导致腿部溃烂
炭疽细菌感染导致腿部溃烂
炭疽细菌感染导致腿部溃烂
在1942年因炭疽细菌感染导致腿部溃烂的老 人 ------张松贤1942年,日军来到金华烧,杀,抢, 掠,许多村民被迫背井离乡,张松贤全家躲到离家 20里外的山上,3个月后才下山。在一次干农活中, 老人的腿被刮了一下,从此起疱变肿,接着肿处开 始溃烂,一烂就是60多年,也痛了60多年。先后 住过6次医院,植了 4次皮,但一直无法根治.
侵华日军731部队遗址
细菌
大肠杆菌
肺炎球菌 皮肤上的细菌
认识作者
郑也夫,1950年生,当代学者, 现为中国人民大学社会学系教授,博 士生导师。主要著作有《西方社会学 史》、《走出囚徒困境》、《代价 论》、《信任论》。本文是作者2003 年5月12日“非典”期间在中国人民 大学的一次精彩的演讲。
根瘤(liú)菌 反刍(chú)
豁( huò)免 觅(mì)食
唾(tuò)液
繁育(yǎn )
词语解释
不计其数:无法计算数字,形容很多。
名副其实:名称、名声与实际符合。
一招鲜吃遍天:P54
一以贯之,豁免:P55
不卑不亢:P56
不瘟不火:P56
束手待毙:P56
砥砺:P56
1932至1945年,日军731部 队对中国的细菌战为中华民族留 下了深深的伤痛。日军731部队 残酷地对中国平民的健康人体用 鼠疫、伤寒、霍乱、炭疽等细菌 和毒气进行活人实验和惨无人道 的活体解剖,先后有120多万名 中国平民惨死。
细菌的性质和特征 1、细菌的历史最古老; 2、细菌无所不在; 3、细菌发挥着重要作用; 4、细菌的不可毁灭性; 5、细菌的生存策略多;
整体感知 重点交流
细菌对人类进步观的挑战表 现在哪些方面?
、生物的进化有两个方向:往 简单化走或者往复杂化走。
、人类所谓的没有美感、不舒坦、 没有尊严、恶心的寄生却是生物 世界中重要的生存策略之一。
炭疽(jū)细菌感染导致腿部溃烂
炭疽细菌感染导致腿部溃烂
炭疽细菌感染导致腿部溃烂
在1942年因炭疽细菌感染导致腿部溃烂的老 人 ------张松贤1942年,日军来到金华烧,杀,抢, 掠,许多村民被迫背井离乡,张松贤全家躲到离家 20里外的山上,3个月后才下山。在一次干农活中, 老人的腿被刮了一下,从此起疱变肿,接着肿处开 始溃烂,一烂就是60多年,也痛了60多年。先后 住过6次医院,植了 4次皮,但一直无法根治.
侵华日军731部队遗址
细菌
大肠杆菌
肺炎球菌 皮肤上的细菌
认识作者
郑也夫,1950年生,当代学者, 现为中国人民大学社会学系教授,博 士生导师。主要著作有《西方社会学 史》、《走出囚徒困境》、《代价 论》、《信任论》。本文是作者2003 年5月12日“非典”期间在中国人民 大学的一次精彩的演讲。
根瘤(liú)菌 反刍(chú)
豁( huò)免 觅(mì)食
唾(tuò)液
繁育(yǎn )
词语解释
不计其数:无法计算数字,形容很多。
名副其实:名称、名声与实际符合。
一招鲜吃遍天:P54
一以贯之,豁免:P55
不卑不亢:P56
不瘟不火:P56
束手待毙:P56
砥砺:P56
1932至1945年,日军731部 队对中国的细菌战为中华民族留 下了深深的伤痛。日军731部队 残酷地对中国平民的健康人体用 鼠疫、伤寒、霍乱、炭疽等细菌 和毒气进行活人实验和惨无人道 的活体解剖,先后有120多万名 中国平民惨死。
八年级语文下册《细菌的启示》第一课时课件 北师大版
走进作者
郑也夫,1950年生,现为中 国人民大学社会学系教授,博士生导师。主要 著作有《走出囚徒困境》、《代价论》、《信 任论》。文化大革命当中,北上黑龙江建设兵 团852农场务农,当过农民,八年半后返回北 京,后考入首都师范大学历史系,1979年, 郑也夫马不停蹄,跳跃式考入中国社会科学院 宗教所,攻读哲学硕士,八十年代中期,郑也 夫奔赴美国,攻下“丹佛”大学社会学硕士, 取得双硕士。他对社会生活的杂质,仍然不愿 睁一只眼闭一只眼。本文是作者2003年5月12 日“非典”期间在中国人民大学的一次精彩的 演讲.
我会读
不计其数 摄( shè)取 名副其 实 当之无愧 反刍( chú) 不可匹 敌 得天独厚 繁衍( yān ) 赤手空拳 不可思议 觅( mì)食 一 以贯之 不卑不亢kànɡ 不瘟(wen)火 束 手待毙 道高一尺魔高一丈 砥( dǐ )砺
举例说明本文运用了哪些说明方法?
列数字
作比较
举例子
分类别
打比方பைடு நூலகம்
主题:本文通过介绍细菌的性质 与特征,以及生物界中的寄生生 存策略,告诉人们对待社会生活 中的寄生行为,不要过于激动烦 恼,要以坚持不懈,持之以恒的 态度,心平气和的与这些不良行 为作漫长的斗争。
讨论:课文共讲了两部分内容,它
们之间有何联系?
细菌
郑也夫
的启示
1.知识能力:识记并理解文中的生 字词,掌握本文的说明方法。 2.过程方法:在阅读探究中了解文 章内涵,掌握本文的说明方法。 3.情感态度:养成科学认识事物的 方法,培养大家从小热爱科学的精 神。。
说明文是客观地说明事物的一种文体,目 的在于给人以知识,或说明事物的状态、 性质、功能、特征,或阐述事理。阅读说 明文注意四个方面的问题:说明的对象及 特征、说明方法、说明语言、说明顺序。 说明方法:举例子、分类别、打比方、列 数据、作比较、下定义、作诠释、摹状貌、 画图表、引用等。说明的顺序:时间顺序、 空间顺序、逻辑顺序。说明文的语言:说 明语言的准确性,是说明文语言的先决条 件。 准确性和多样性、灵活性并不矛盾。
八年级语文下册第二单元3细菌的启示教学课件北师大版_191

总结全文,拓展延伸
写一写: 读了本文,你会对细菌有了全
新的认识。请想像一下:假如没有 了细菌,这个世界会怎样?把你的 想像用具体生动的语言表达出来。
品读课文,理解主题
◆一粒普通的泥土中有几亿个细菌,人的一滴唾液中有几百万个细菌, 的10%是由细菌构成的。
细菌与我们的生活联系竟如此紧密!从数量上看,细菌不知要比人 可以说,我们生活在细菌的包围之中。当然,这种包围对我们并没有多
◆你看到天上有一只鸽子在飞,那哪是一只鸽啊,那是一个飞行的动物 一只鸽如此,一个人何尝不也是这样。我们的头发里有细菌,我们
菌,我们的肠胃里有细菌,看到一个人在走,就好像一个动物园在走— 不能不承认的事实。
悟读课文,探究难点
本文有对常识的颠覆和批判,有对话性的交流和雄辩的表 述,写出了作者的深入思考。以下面三句话为例,说一说你的 思考(任选一句)。
●我们走到最复杂的巅峰是偶然,只是偶然,连幸运都很难说。 ●复杂是它的幸运吗?进步一定能使物种长存吗?这要两说的。 ●尽管它看着不舒服,没有美感,没有尊严,恶心……你会觉得 这种策略真是鬼聪明。
第二单元 · 第3课
细菌的启示
新课导入
新课导入
新课导入
新课导入
新课导入
新课导入
走近作者
郑也夫:1950年生,
中国人民大学社会学系教授 主要著作有《西方社会学史 困境》、《代价论》、《信 作者2003年5月12日“非典 民大学的一次精彩的演讲。
检查预习
砥砺 喷嚏 ቤተ መጻሕፍቲ ባይዱ峰 根瘤菌 反刍 豁免 发酵 繁衍 摄取 觅食 笨拙 唾液 束手待毙 不卑不亢 不瘟不火
初读课文,整体感知
再读课文,说说细菌对人 类进步观的挑战表现在些方面:
北师大版八年级语文下细菌的启示

说明文的分类 从对象上:事物说明文、事理 说明文 从语言上:生动性说明文、平 实性说明文 说明文的结构 总分式: 递进式:
细菌的性质和特征
1、细菌的历史最古老; 2、细菌无所不在; 3、细菌发挥着重要作用; 4、细菌的不可毁灭性; 5、细菌的生存策略多;
细菌对人类进步观的挑战表现在 哪些方面?
假如世界上的细菌被全部消灭, 世界将会是什么样子?
1、人类的进步与细菌的简单化、退化。 2、人类所谓的没有美感、不舒服、没有 尊严、恶心的寄生却是生物世界中重要 的生存策略之一。
朗读课文 整体感知
交流心得: 你对细菌有了哪些新的认识?哪些让你最感 兴趣?请找出有关课文内容读一读。 提示:注意课文每段都有中心句。尝试用自 己的话交流读书体会
作者为什么写这篇文章,主旨是什 么?
说明文
说明文是以说明为主要 表达方式的一种文体,或介 绍事物的状态、性质、功能; 或阐明事理,目的是给人以 知识。
对象:介绍事物、阐明事理 特征:区别于其它事物的本质东西 方法:举例子、列数字、分类别、作比 较、打比方、引用、下定义、作诠释、画 图表、摹状貌等 顺序:时间顺序、空间顺序、逻辑顺序。 语言:准确、简明
问题探究:
1、举例说明这篇演讲如何将抽象,陌
生的科学知识化为明白易懂的感性表 达?
通过讲故事,形象比喻,拟人化写法, 形象命名,接通日常化经验,通俗的口 语表达等手法。
合作探究
1、课文共讲了两部分内容,它们之间有何联 系? 2、文章如何安排详略的? 3、细菌对传统的进化论的挑战含义是什么?
拓展延伸:
(提示:可从课文哪一段看出演讲的目的?)
明确:最后一段。本文通过介绍细菌 的性质与特征,以及生物界中的寄生 生存策略,告诉人们对待社会生活中 的寄生行为,不要过于激动烦恼,要 以坚持不懈、持之以恒的态度,心平 气和地与之作漫长的斗争。
北师大版编号5细菌的启示课件
作者先从细菌的性质与特征谈起,谈了细 菌的古老、重要作用、不可毁灭、生存策略等 问题,从而涉及到人类社会的寄生现象。寄生 现象在人类社会同样古老,要同寄生行为作斗 争,不是一朝一夕就能完成的,作者让大家采 取“不卑不亢、不瘟不火、不喜不哀”的态度, 是要人们心平气和地去消灭“寄生虫”们,几 千年的陋习不可能完全铲除;同时与寄生行为 作斗争,还有利与人们激起斗志,磨练意志, 开动脑筋,增加智慧。
4.画图表 为了把复杂的事物说清楚, 还可以采用图表法,来弥补单用文字表 达的缺欠,对有些事物解说更直接、更 具体。 5.作诠释 从一个侧面,就事物的某一 个特点做些解释,这种方法叫诠释法。 使说明更通俗易懂。
6.打比方 利用两种不同事物之间的相似 之处作比较,以突出事物的性状特点,增 强说明的形象性和生动性的说明方法叫做 打比方。 说明文中的打比方的说明方法,同修辞格 上的比喻是一致的。不同的是,比喻修辞 有明喻、暗喻、和借喻,而说明多用明喻 和暗喻,借喻则不宜使用。 7.摹状貌 为了使被说明对象更形象、具体, 可以进行状貌摹写,这种说明方法叫摹状 貌。(和描写要区分开,两者虽一样,不过是 在不同的文体中的。)
细菌给了我们哪些启示?
首先我们应该认识到,人类不可 能彻底战胜细菌和 病毒,因此,一 些灾难性事件将与人类社会长期共存。 其次,在灾难面前,我们不能无 所作为,要动员全社会的力量,齐心 协力,从容应对,战胜灾难。
合作探究一
1.朗读“当我们从生物的 世界到人类的社会‥‥‥开始 道高一尺魔高一丈的较量。” 小组讨论:作者对人类社会中 的寄生现象持怎样的态度?
说明文的分类 从对象上:事物说明文、事理说明文 从语言上:生动性说明文、平实性说 明文 说明文的结构 总分式 递进式
读准下列词语
推荐八年级语文下册第二单元3细菌的启示教学课件北师大版
第二单元 · 第3课
细菌的启示
精选
最新中小学课件
1
新课导入
最新中小学课件
2
新课导入
最新中小学课件
3
新课导入
最新中小学课件
4
新课导入
最新中小学课件
5
新课导入
最新中小学课件
6
新课导入
最新中小学课件
7
走近作者
郑也夫:1950年生,当代学者,现为
中国人民大学社会学系教授,博士生导师。 主要著作有《西方社会学史》、《走出囚徒 困境》、《代价论》、《信任论》。本文是 作者2003年5月12日“非典”期间在中国人 民大学的一次精彩的演讲。
最新中小学课件
8
检查预习
砥砺 发酵
喷嚏 繁衍
颠峰 摄取
根瘤菌 觅食
反刍 笨拙
豁免 唾液
束手待毙 易错字:
不卑不亢
不瘟不火
不计其数
一以贯之
名副其实
束手待毙
不可思议
9
最新中小学课件
初读课文,整体感知
说说细菌有哪些性质和特征?分别用了哪 些说明方法?(试举例说明):
特征一:“生物界元老”列数字,作比较。 特征二:“无所不在”列数字,举例子,作比较。 特征三:“发挥重要作用”举例子。 特征四:“不可毁灭性”举例子,列数字,作比较,打比方。 特征五:“寄生”打比方,举例子,列数字。 最新中小学课件 10
最新中小学课件
12
品读课文,理解主题
◆一粒普通的泥中有几亿个细菌,人的一滴唾液中有几百万个细菌,甚至人体体重
的10%是由细菌构成的。
细菌与我们的生活联系竟如此紧密!从数量上看,细菌不知要比人类强大多少倍, 可以说,我们生活在细菌的包围之中。当然,这种包围对我们并没有多大伤害。
细菌的启示
精选
最新中小学课件
1
新课导入
最新中小学课件
2
新课导入
最新中小学课件
3
新课导入
最新中小学课件
4
新课导入
最新中小学课件
5
新课导入
最新中小学课件
6
新课导入
最新中小学课件
7
走近作者
郑也夫:1950年生,当代学者,现为
中国人民大学社会学系教授,博士生导师。 主要著作有《西方社会学史》、《走出囚徒 困境》、《代价论》、《信任论》。本文是 作者2003年5月12日“非典”期间在中国人 民大学的一次精彩的演讲。
最新中小学课件
8
检查预习
砥砺 发酵
喷嚏 繁衍
颠峰 摄取
根瘤菌 觅食
反刍 笨拙
豁免 唾液
束手待毙 易错字:
不卑不亢
不瘟不火
不计其数
一以贯之
名副其实
束手待毙
不可思议
9
最新中小学课件
初读课文,整体感知
说说细菌有哪些性质和特征?分别用了哪 些说明方法?(试举例说明):
特征一:“生物界元老”列数字,作比较。 特征二:“无所不在”列数字,举例子,作比较。 特征三:“发挥重要作用”举例子。 特征四:“不可毁灭性”举例子,列数字,作比较,打比方。 特征五:“寄生”打比方,举例子,列数字。 最新中小学课件 10
最新中小学课件
12
品读课文,理解主题
◆一粒普通的泥中有几亿个细菌,人的一滴唾液中有几百万个细菌,甚至人体体重
的10%是由细菌构成的。
细菌与我们的生活联系竟如此紧密!从数量上看,细菌不知要比人类强大多少倍, 可以说,我们生活在细菌的包围之中。当然,这种包围对我们并没有多大伤害。
北师大版八下语文《细菌的启示》
合作探究
本篇演讲是如何紧紧抓住听众心 理的? (1)自问自答,引起听众的注意 和兴趣,给人一种对话交流的语 气。 (2)内容是听众关注的,新奇的 事理,抓住听众好奇的心理。
品 一 品
演讲结束语说:“我愿意 以危 机时刻讨论无用之学的执著和从 容,达到与同学们在精神和意志 上的相互砥砺。“结合课文中的 语句具体谈谈你的理解。
当之无愧: 担当起某个荣誉或职务不觉得愧疚. 当,承担,承受. 道高一尺,魔高一丈:正气难以修得,比喻事物兴起, 又有事物超过其上.道,指正气;魔,指邪气. 不可匹敌: 没人能与他实力相当,形容有万夫之 勇,不可战胜。 赤手空拳: 指没有任何可以凭借的东西或形容两 手空空;一无所有。 犬儒主义: 指无所作为. 砥砺:勉励.砥,磨刀石. 豁免: 免除.
1932至1945年,日军731部 队对中国的细菌战为中华民族留 下了深深的伤痛。日军731部队 残忍地对中国平民的健康人体用 鼠疫、伤寒、霍乱、炭疽等细菌 和毒气进行活人实验和惨无人道 的活体解剖,先后有120多万名 中国平民惨死。
在1942年因炭疽细菌感染导致腿部溃烂的老 人 ------张松贤1942年,日军来到金华烧,杀,抢, 掠,许多村民被迫背井离乡,张松贤全家躲到离家 20里外的山上,3个月后才下山。在一次干农活中, 老人的腿被刮了一下,从此起疱变肿,接着肿处开 始溃烂,一烂就是60多年,也痛了60多年。先后 住过6次医院,植了 4次皮,但一直无法根治.
生字注音
砥砺(dǐ )(
根瘤(liú )菌 豁( huò)免 唾( )液 tuò
) lì
喷嚏( ) tì
反刍( ) chú 觅( )食 mì 繁衍(yǎn )
发酵( jiào )摄取( shè)咀嚼( jǔjué
- 1、下载文档前请自行甄别文档内容的完整性,平台不提供额外的编辑、内容补充、找答案等附加服务。
- 2、"仅部分预览"的文档,不可在线预览部分如存在完整性等问题,可反馈申请退款(可完整预览的文档不适用该条件!)。
- 3、如文档侵犯您的权益,请联系客服反馈,我们会尽快为您处理(人工客服工作时间:9:00-18:30)。
· 识记记词 ●名副其实 不卑不亢 砥砺 喷嚏 奶酪 繁衍 笨拙
●
打
道高一尺 魔高一丈 束手待毙 不瘟不火 一以贯之 不可思议 得天独厚
研讨课文
速读课文1-11段 思考: 1、世界上的物种有哪五类? 2、细菌有哪些性质和特征? 3、 什么是寄生?“什么叫“寄生”? 所谓寄生……吸收到它的身体里。” 这段中运用了什么修辞手法?有什么 作用? 学生先自找,再交流,展示。
细菌的启示
郑也夫
· 认识作者
郑也夫,1950年生,当代学者, 现为中国人民大学社会学系教授,博 士生导师。主要著作有《西方社会学 史》、《走出囚徒困境》、《代价 论》、《信任论》。本文是作者2003 年5月12日“非典”期间在中国人民大 学的一次精彩的演讲。
题解:这是一篇演讲稿,是郑也夫教授于
2003.5.12在中国人民大学做的露天演讲。 演讲背景是:2003年一场传染病肆虐全球。 它传染性极强,病情进展迅速,严重者出现 快速发展的呼吸系统衰竭。这种传染病先后 被称为“非典”,“SARS”,现在又有人 建议将其命名为“传染性冠状病毒肺炎”。 这场传染病让人们处于惶惶不安之中,郑也 夫教授这次演讲,向人们介绍了细菌的特点 以及由细菌的特点得到的启示。
明确本节学习目标、学习内容。
• 1、了解细菌的性质和特征。 • 2.掌握说明文中的多种说明方法。 • 3.体会本文做为一篇说明文语言的准 确性和做为一篇演讲稿语言生动活泼 的特点。 重点、难点及解决办法: 目标2、3。 通过学生自学、合作探究、教师点拨的 综合运用多种方法的方式解决。
整体感知、解决字词
语言表达特点 举例说明
• 大量的通俗口语表达。 • 使用听众熟悉的,典雅贴切的书 面词汇。 • 因大词小用和事物间的巧妙联系 等产生风趣幽默感。 • 由于简短、明快、风趣、设问、 感叹,使其充满对话、交流的语 气。
还要注意,除了列数字能充 分说明“准确性”这一特点外, 还有其他方式。 例句1:“抗生素时代” 到来了,并且一度以为已经大获 全胜。(副词、动词的准确使用) 例句2:这类病毒必须在 人口密集的地方存活。(副词的 准确使用)
细菌的性质和特征
1、细菌的历史最古老; 2、细菌无所不在; 3、细菌发挥着重要作用; 4、细菌的不可毁灭性; 5、细菌的生存策略多;(细菌的生存 策略是寄生)
解析:作者用了一种“拟人化” 的修辞手法。细菌的特点是看不 见,摸不着的,作者用“拟人化” 的修辞手法将抽象的科学概念形 象具体化,好像细菌是有意志、 有目的的人,还活灵活现,就在 你面前似的。
思考:文章为什么详写第四、五 个特征?
先明确这是主要特征,至于为 下文做铺垫下节课再补充。
研讨本部) 列数字; 作比较; 举例子; 打比方; 分类别。
研讨语言特点,问题探究: 1、举例说明这篇演讲如何将抽象, 陌生的科学知识化为明白易懂的 感性表达? 通过讲故事,形象比喻,拟人 化写法,形象命名,接助日常化 经验,通俗的口语表达等手法。 2、本篇演讲的语言表达有何特点? 举例说明。
布置作业:
• 预习课文第二部分,先行解决 生字词。
●
打
道高一尺 魔高一丈 束手待毙 不瘟不火 一以贯之 不可思议 得天独厚
研讨课文
速读课文1-11段 思考: 1、世界上的物种有哪五类? 2、细菌有哪些性质和特征? 3、 什么是寄生?“什么叫“寄生”? 所谓寄生……吸收到它的身体里。” 这段中运用了什么修辞手法?有什么 作用? 学生先自找,再交流,展示。
细菌的启示
郑也夫
· 认识作者
郑也夫,1950年生,当代学者, 现为中国人民大学社会学系教授,博 士生导师。主要著作有《西方社会学 史》、《走出囚徒困境》、《代价 论》、《信任论》。本文是作者2003 年5月12日“非典”期间在中国人民大 学的一次精彩的演讲。
题解:这是一篇演讲稿,是郑也夫教授于
2003.5.12在中国人民大学做的露天演讲。 演讲背景是:2003年一场传染病肆虐全球。 它传染性极强,病情进展迅速,严重者出现 快速发展的呼吸系统衰竭。这种传染病先后 被称为“非典”,“SARS”,现在又有人 建议将其命名为“传染性冠状病毒肺炎”。 这场传染病让人们处于惶惶不安之中,郑也 夫教授这次演讲,向人们介绍了细菌的特点 以及由细菌的特点得到的启示。
明确本节学习目标、学习内容。
• 1、了解细菌的性质和特征。 • 2.掌握说明文中的多种说明方法。 • 3.体会本文做为一篇说明文语言的准 确性和做为一篇演讲稿语言生动活泼 的特点。 重点、难点及解决办法: 目标2、3。 通过学生自学、合作探究、教师点拨的 综合运用多种方法的方式解决。
整体感知、解决字词
语言表达特点 举例说明
• 大量的通俗口语表达。 • 使用听众熟悉的,典雅贴切的书 面词汇。 • 因大词小用和事物间的巧妙联系 等产生风趣幽默感。 • 由于简短、明快、风趣、设问、 感叹,使其充满对话、交流的语 气。
还要注意,除了列数字能充 分说明“准确性”这一特点外, 还有其他方式。 例句1:“抗生素时代” 到来了,并且一度以为已经大获 全胜。(副词、动词的准确使用) 例句2:这类病毒必须在 人口密集的地方存活。(副词的 准确使用)
细菌的性质和特征
1、细菌的历史最古老; 2、细菌无所不在; 3、细菌发挥着重要作用; 4、细菌的不可毁灭性; 5、细菌的生存策略多;(细菌的生存 策略是寄生)
解析:作者用了一种“拟人化” 的修辞手法。细菌的特点是看不 见,摸不着的,作者用“拟人化” 的修辞手法将抽象的科学概念形 象具体化,好像细菌是有意志、 有目的的人,还活灵活现,就在 你面前似的。
思考:文章为什么详写第四、五 个特征?
先明确这是主要特征,至于为 下文做铺垫下节课再补充。
研讨本部) 列数字; 作比较; 举例子; 打比方; 分类别。
研讨语言特点,问题探究: 1、举例说明这篇演讲如何将抽象, 陌生的科学知识化为明白易懂的 感性表达? 通过讲故事,形象比喻,拟人 化写法,形象命名,接助日常化 经验,通俗的口语表达等手法。 2、本篇演讲的语言表达有何特点? 举例说明。
布置作业:
• 预习课文第二部分,先行解决 生字词。
